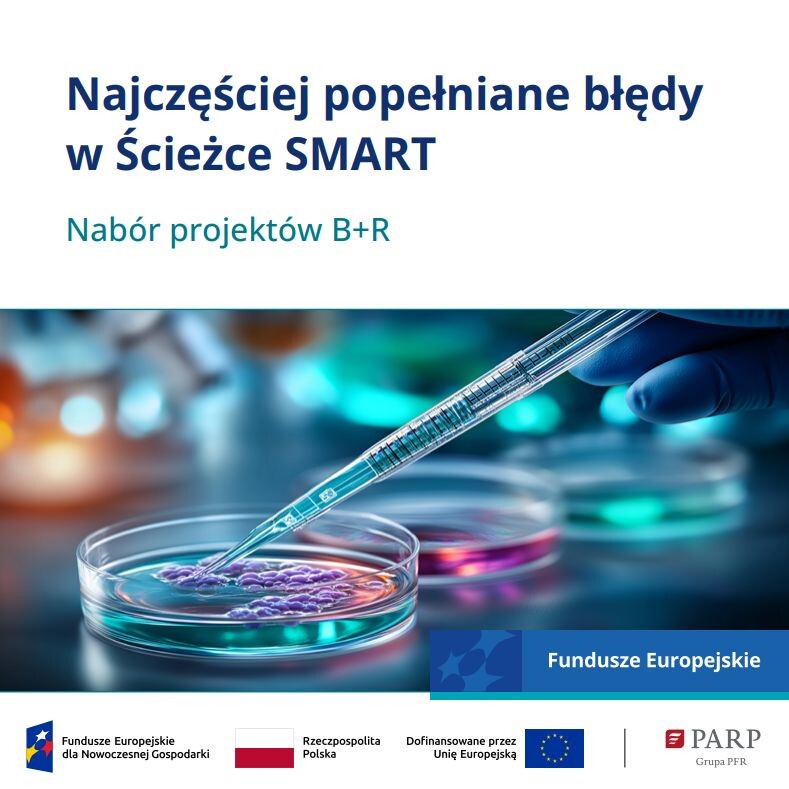
Najczęściej popełniane błędy w Ścieżce SMART

Udzielamy informacji o programach pomocowych realizowanych przez PARP.
Cluster Managment Standards (EN)
Pobierz wybrany format publikacji:
Th is report presents cluster management standards that should be understood as the code setting basic requirements for coordinators’ practice a nd conduct in running a cluster while taking into account, inter alia , the best practices identified in Poland and abroad.
Most recent knowledge about the meth ods and systems for evaluation of c luster management processes has been used to provide cluster coordinators with a tool for effective improve ment of their management activities, and with n ecessary guidance to implement the standards. A des k research carried out prior to the development of cluster management standards, made it possible to acquire extensive knowledge o n the quality requirements towards cluster organisations providing a basis for standard setting .
The group of recipients of the proposed s tandards includes cluster coordinators (organisations which manage clusters and undertake actions for their development) and institutions responsible for the cluster policy at central and regional level s. For cluster constituents such as enterprises (in part icular, SMEs), implementation of the standards means access to improved quality service s
Spis treści
1. Preface
2. Introduction
3. Development process of cluster management standards
4. Cluster management standards
5. Resources
6. Processes
7. Services rendered to cluster members
8. External Collaboration